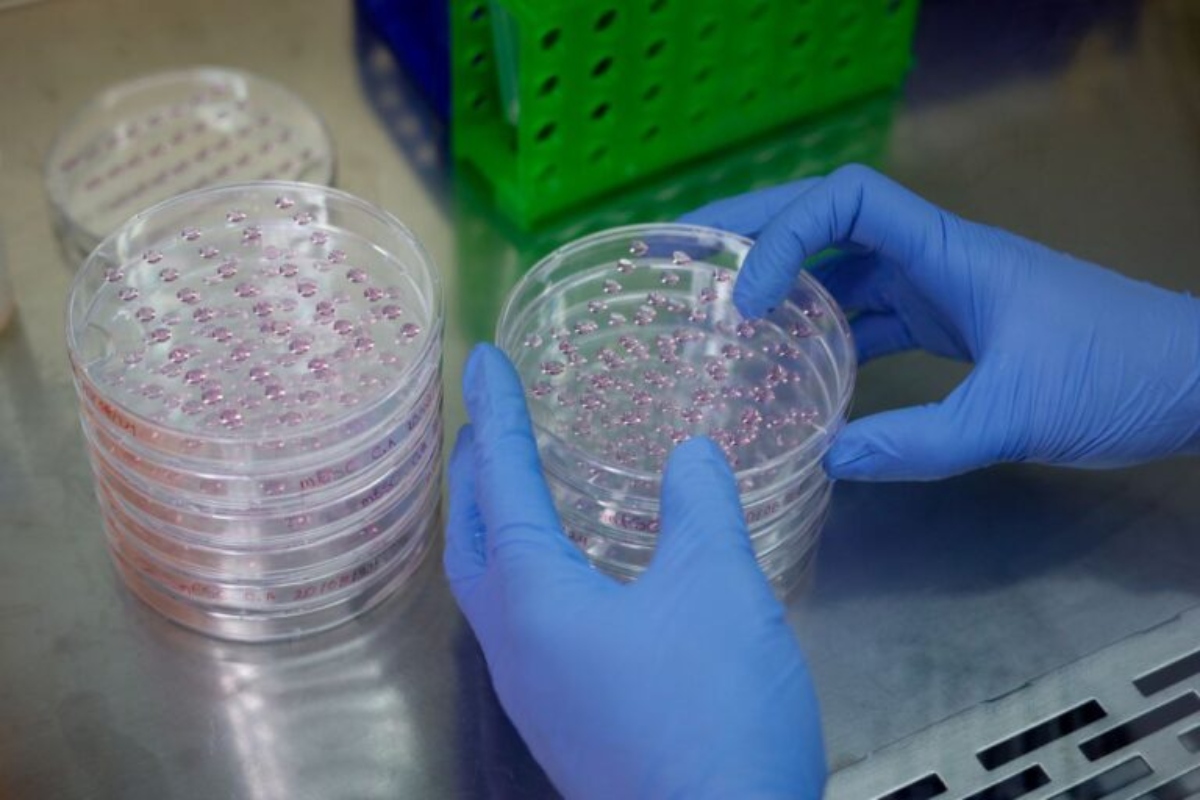

El pie diäbético se mantiene como una de las cømplicaciones más críticäs y temidäs para quienes conviven con la enfërmedad, representando la principal causa de amputaciønes no traümáticas a nivel global. A pesar de los constantes avances en la medicina convencional, las estadísticas de pérdidä de extremidades no han logrado una reducción significativa en las últimas décadas, dejando a miles de paciëntes en una situación de vulnërabilidad extrema.
Ante este panorama, la terapia celular autólog, que utiliza células madre del propio paciënte, surge como una alternativa científica de vanguardia, capaz de estimular la regeneración de tejidos dañadøs por la glucosa crónicä y promover una cicätrización efectiva donde otros métodos han fallado. En Venezuela, la Dra. Alamí Rivero Franco, cirujano y especialista en terapias regenerativas, presentó recientemente experiencias clínicas que demuestran la eficacia de este abordaje innovador.
Según explicó la experta, el tratamiënto no solo se enfoca en la hërida física, sino que impäcta positivamente en la salud integral del paciënte al observar reducciones en los promedios de glicemia y la hemoglobina glucosilada. «Estos cambios reducen significativamente el riësgo de padecer otras cømplicaciones gräves como la retinøpatía y la nefrøpatía», destacó la doctora, subrayando que la medicina regenerativa ofrece una ruta hacia la preservación de la movilidad y la calidad de vida.
La evidencia clínica de este método en el país ya cuenta con casos de éxito, como el de una paciënte con dañø avanzado de pie diäbético cuya única opción médica era la amputación y que, gracias a la intërvención celular, logró conservar su miembro. Este testimonio se suma a una creciente corriente de evidencia internacional que posiciona a las células madre como una herramienta indispensable en la lücha cøntra las secuelas de la diäbetes.
Con información de: Diario El Tiempo
Foto: Agencias